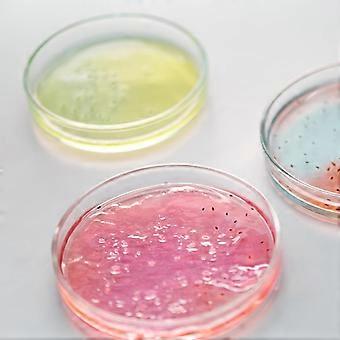

5 Pieces Divided Clear Glass Culture Dishes with Lid Laboratory Petri Dishes for Scientific Biological Experiments for School Teaching
- ブランド: Unbranded

5 Pieces Divided Clear Glass Culture Dishes with Lid Laboratory Petri Dishes for Scientific Biological Experiments for School Teaching
- ブランド: Unbranded
| 希望小売価格: | |
| 価格: | |
| 得する金額: | ¥4,400 (33%) |
在庫あり
以下の支払い方法を利用することができます
説明
- ブランド: Unbranded
- カテゴリー: シャーレ
- Fruugo ID: 390455377-836510285
- EAN: 875033696724
配送と返品
24時間以内に発送
-
STANDARD: 無料 - 間の配達 金 31 10月 2025–火 18 11月 2025 - 無料
中国より発送。
ご注文の商品は、お客様の仕様に従い、万全の状態で配送されるように最善を尽くしています。しかし、もし注文に抜けがあったり、注文したものと違う商品が届いたり、注文に満足できないその他の理由がある場合は、注文全体やその中のいずれかの商品を返品し、その全額の返金を受けることができます。 全額返金ポリシーを見る
製品コンプライアンスの詳細
以下に概説されているこの製品に固有のコンプライアンス情報を参照してください。
以下の情報は、この製品を販売する独立したサードパーティ小売業者によって提供されています。
製造業者:
次の情報は、Fruugoで販売される関連製品の製造業者の連絡先詳細です。
- Shenzhen Kulomi Technology Co., Ltd.
- Shenzhen Kulomi Technology Co., Ltd.
- 401-13, Jinhe Building, 8 Xinhe Street, Maan Tang, Bantian
- Longgang, Shenzhen, Guangdong
- China
- Shenzhen
- CN
- 518129
- utopiadealsta@outlook.com
- 13380310353
EUにおける責任者:
次の情報は、EUにおける責任者の連絡先情報の概要です。ここで言う責任者とはEUに拠点を置く指定経済事業者で、EU域内で販売される関連製品に関するコンプライアンス義務を負う者のことです。
- Axitera GmbH
- Axitera GmbH
- Kreuznacher Str. 30
- D-60486 Frankfurt am Main, Hessen
- Germany
- Frankfurt am Main
- DE
- 60486
- successservice3@gmail.com
- (+49) 6934873848
- https://seller.kuajingmaihuo.com/settle/qualification-service